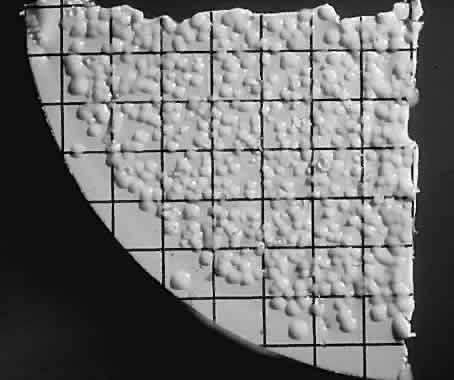

1. Essman TF, Flynn HW Jr, Smiddy WE et al: Treatment outcomes in a 10-year study of endogenous fungal endophthalmitis. Ophthalmic Surg Lasers 28:185, 1997 2. Walsh TJ: Emerging fungal pathogens: Evolving challenges to immunocompromised
patients. In Scheld WM, Armstrong D, Hughes JM (eds): Emerging
Infections 1, chap. 15. Washington DC: ASM Press, 1998 3. Kresloff MS, Castellarin AA, Zarbin MA: Endophthalmitis. Surv Ophthalmol 43:193, 1998 4. Martinez-Vazquez C, Fernandez-Ulloa J, Bordon J et al: Candida albicans endophthalmitis in brown heroin addicts: Response to early vitrectomy
preceded and followed by antifungal therapy. Clin Infect Dis 27:1130, 1998 5. Getnick RA, Rodrigues MM: Endogenous fungal endophthalmitis in a drug addict. Am J Ophthalmol 77:680, 1974 6. Shankland GS, Richardson MD: Source of infection in Candida endophthalmitis in drug addicts. Br Med J (Clin Res) 292:1106, 1986 7. Servant JB, Dutton GN, Ong-Tone L et al: Candidal endophthalmitis in Glaswegian heroin addicts: Report of an epidemic. Trans Ophthalmol Soc UK 104:297, 1985 8. Hutchins GP: Fusarium endophthalmitis in an intravenous drug abuser. Am J Ophthalmol 122:119, 1996 9. Heinemann MH, Bloom AF, Horowitz J: Candida albicans endophthalmitis in a patient with AIDS: Case report. Arch Ophthalmol 105:1172, 1987 10. Denning DW, Armstrong RW, Fishman M, Stevens DA: Endophthalmitis in a patient with cryptococcosis and AIDS who was treated
with itraconazole. Rev Infect Dis 13: 126, 1991 11. Kirkpatrick CH: Host factors in defense against fungal infections. Am J Med 77(Suppl 4D):1, 1984 12. Behlau I, Baker AS: Fungal infections of the eye. In Albert DA, Jakobiec
F (eds): Principles and Practice of Ophthalmology, pp 4884–4917. Philadelphia: WB
Saunders, 2000 13. Gass JDM: Stereoscopic Atlas of
Macular Diseases: Diagnosis and Treatment, pp 601–736. St Louis: Mosby, 1997 13. Gass JDM:Stereoscopic Atlas of Mascular Diseases: Diagnosis and Treatment, pp 601–736. St
Louis: Mosby. 1997 14. Regillo CD, Brown GC, Flynn HW Jr (eds): Vitreoretinal Disease: The Essentials, pp 393–438. New York: Thieme, 1999 15. Louria DB, Dincen P: Amphotericin B in the treatment of disseminated moniliasis. JAMA 174:273, 1960 16. Gold W, Stout HA, Pagano JF, Danovick R: Amphotericins A and B: antifungal
antibiotics produced by a streptomycete: I. In vitro studies. In Welch
H, Marti-Ibanez F (eds): Antibiotics Annual, 1955–1956, p 579. New
York: Medical Encyclopedia, 1956 17. Butler WT: Pharmacology, toxicity and therapeutic usefulness of amphotericin B. JAMA 195:371, 1966 18. Kotler-Brajtburg J, Price HD, Medoff G et al: Molecular basis for the selective toxicity of amphotericin B for yeast
and filipin for animal cells. Antimicrob Agents Chemother 5:377, 1974 19. Bennett JE: Chemotherapy of systemic mycoses. N Engl J Med 290, 1974 20. Green WR, Bennett JE, Goos RD: Ocular penetration of amphotericin B: A report of laboratory studies and
a case report of post surgical cephalosporium endophthalmitis. Arch Ophthalmol 73:769, 1965 21. Stern WH, Tamura E, Jacobs RA et al: Epidemic post surgical Candida parapsilosis endophthalmitis: Clinical findings and management of 15 consecutive cases. Ophthalmology 92:1701, 1985 22. Fisher JF, Taylor AT, Clark J et al: Penetration of amphotericin B into the human eye. J Infect Dis 147:164, 1983 23. O'Day DM, Head WS, Robinson RD et al: Intraocular penetration of systemically
administered antifungal agents. Curr Eye Res 4:131, 1985 (published
erratum appears in Curr Eye Res 5:547, 1986) 24. Barza M: Editorial response: Treatment options for candidal endophthalmitis. CID 27:1134, 1998 25. Axelrod AJ, Peyman GA, Apple DJ: Toxicity of intravitreal injection of amphotericin B. Am J Ophthalmol 76:578, 1973 26. Tremblay C, Barza M, Szoka F et al: Reduced toxicity of liposome-associated amphotericin B injected intravitreally
in rabbits. Invest Ophthalmol Vis Sci 26:711, 1985 27. McGetrick JJ, Peyman GA, Nyberg MA: Amphotericin B methyl ester: Evaluation for intravitreous use in experimental
fungal endophthalmitis. Ophthalmic Surg 10:25, 1979 28. Barza M Baum J, Tremblay C et al: Ocular toxicity of intravitreally injected liposomal amphotericin B in
rhesus monkey. Am J Ophthalmol 100:259, 1985 29. Axelrod AJ, Peyman GA: Intravitreal amphotericin B treatment of experimental fungal endophthalmitis. Am J Ophthalmol 76:584, 1973 30. Doft BH, Weiskopf J, Nilsson-Ehle I, Wingard LB Jr: Amphotericin clearance in vitrectomized versus nonvitrectomized eyes. Ophthalmology 92:1601, 1985 31. Wingard LB Jr, Zurlaveff J, Doft B et al: Intraocular distribution of intravitreally administered amphotericin B
in normal and vitrectomized eyes. Invest Ophthalmol Vis Sci 30:2184, 1989 32. Perraut LE Jr, Perraut LE, Bleiman B, Lyons J: Successful treatment of Candida albicans endophthalmitis with intravitreal amphotericin. Br Arch Ophthalmol 99:1565, 1981 33. Stern WH, Tamura E, Jacobs RA et al: Epidemic post surgical Candida parapsilosis endophthalmitis: Clinical findings and management of 15 consecutive cases. Ophthalmology 92:1701, 1985 34. Minogue MJ, Playfair TJ, Gregory-Roberts JC, Robinson LP: Cure of Paecilomyces endophthalmitis with multiple intravitreal injections of amphotericin
B: Case report. Arch Ophthalmol 107:1281, 1989 35. Huang K, Peyman GA, McGetrick J: Vitrectomy in experimental endophthalmitis: I. Fungal infections. Ophthalmic Surg 10:84, 1979 36. Stern GA, Fetkenhour CL, O'Grady RB: Intravitreal amphotericin B treatment of Candida endophthalmitis. Arch Ophthalmol 95:89, 1977 37. Snip RC, Michels RG: Pars plana vitrectomy in the management of endogenous Candida endophthalmitis. Am J Ophthalmol 82:699, 1976 38. Salmon JF, Patridge BM, Spalton DJ: Candida endophthalmitis in a heroin addict: A case report. Br J Ophthalmol 67:306, 1983 39. Kroll P, Emmerich KH, Fegeler W: Candida albicans endophthalmitis: Ergebnisse de Pars Plana Vitrektomie ohne intraokulare
antimymkotische Therapie. Klin Monatsbl Augenheilkd 184:104, 1984 40. Furia M, Parent de Curzon H, Campinchi R: Evolution favorable d'une endophthalmie bilaterale a Candida albicans: Interet de la vitrectomie precoce. J Fr Ophthalmol 7:689, 1984 41. Mersch-Ausset MH, Salvanet-Bouchara A, Forestier F et al: Etude angiographique et vitrectomie diagnostique et therapeutique au cors
d'une endoptalmie a Candida albicans chez une heroinomane. Bull Soc Ophtalmol Fr 86:19, 1986 42. Barrie T: The place of elective vitrectomy in the management of patients with Candida endophthalmitis. Graefes Arch Clin Exp Ophthalmol 225:107, 1987 43. Dunn ET, Mansour AM: Retinal striae as a sign of resolving Candida chorioretinitis. Graefes Arch Clin Exp Ophthalmol 226:591, 1988 44. Rennie CJ, Johnson J, Farah S, Hellman L: Disseminated candidiasis due to amphotericin B-resistant Candida albicans. J Infect Dis 165:761, 1992 45. Hamory JN: Endophthalmitis caused by non-albicans Candida. Rev Infect Dis 13:281, 1991 46. Edwards JE Jr, Montgomerie JZ, Ishida K et al: Experimental hematogenous endophthalmitis due to Candida: Species variation in ocular pathogenicity. J Infect Dis 155:294, 1977 47. McQuillen DP, Zingman BS, Meunier F, Levitz SM: Invasive fungal infections due to Candida krusei: Report of 10 cases of fungemia that include three cases of endophthalmitis. Clin Infect Dis 14:472, 1992 48. Edwards JE Jr, Montgomerie JZ, Ishida K et al: Experimental hematogenous endophthalmitis due to Candida: Species variation in ocular pathogenicity. J Infect Dis 135:294, 1977 49. Tassel D, Madoff MA: Treatment of Candida sepsis and Cryptococcus meningitis with 5-fluorocytosine: A new antifungal agent. JAMA 206:830, 1968 50. Diasio RB. Bennett JE, Myers CE: Mode of action of 5-fluorocytosine. Biochem Pharmacol 27:703, 1978 51. Walsh A, Haft DA, Miller MH et al: Ocular penetration of 5-fluorocytosine. Invest Ophthalmol Vis Sci 17:691, 1978 52. Drouhet E, Mercier-Soucy L, Montplaisir S: Sensibilite et resistance des levures pathogenes aux 5-fluoropyrimidines: I. Relation
entre les phenotypes de resistance a la 5-fluorocytosine, le
serotype de Candida albicans, et l'ecologie de differentes especes de Candida d'origine humaine. Ann Microbiol (Paris) 126B:25, 1975 53. Shadomy S: Further in vitro studies with 5-fluorocytosine, Infect Immun 2:484, 1970 54. Medoff G, Comfort M, Kobayashi GS: Synergistic action of amphotericin B and 5-fluorocytosine against yeast-like
organisms. Proc Soc Exp Biol Med 138:571, 1971 55. Montgomerie JZ, Edwards JE Jr, Guze LB: Synergism of amphotericin B and 5-fluorocytosine for Candida species. J Infect Dis 132:82, 1975 56. Cohen M, Montgomerie JZ: Hematogenous endophthalmitis due to Candida tropicalis: Report of two cases and review. Clin Infect Dis 17:270, 1993 57. Yoshizumi MO, Silverman C: Experimental intravitreal 5-fluorocytosine. Ann Ophthalmol 17:58, 1985 58. Dixon D, Shadomy S, Shadomy JH et al: Comparison of the in vitro antifungal activities of miconazole and a new imidazole R 41, 400. J Infect Dis 138:245, 1978 59. Jodan WM, Bodey GP, Ridriguez V et al: Miconazole therapy for treatment of fungal infections in cancer patients. Antimicrob Agents Chemother 16:792, 1979 60. Blumenkranz MD, Stevens DA: Therapy of endogenous fungal endophthalmitis: Miconazole or amphotericin
B for coccidioidal and candidal infection. Arch Ophthalmol 98: 1216, 1980 61. Gallo J, Grunstein H, Clifton-Bligh et al: Miconazole in fungal endophthalmitis. Lancet 1:53, 1982 62. Fainstein V, Bodey GP: Cardiorespiratory toxicity due to miconazole. Ann Intern Med 93:432, 1980 63. Niell HB: Miconazole carrier solution, hyperlipidemia and hematologic problems. N Engl J Med 296:1479, 1977 64. Lutwick KI, Galgiani JN, Johnson RH, Stevens DA: Visceral fungal infections due to Petriellidium boydii (Allescheria boydii): In vitro drug sensitivity studies. Am J Med 61:632, 1976 65. Jones DB: Therapy of postsurgical fungal endophthalmitis. Ophthalmology 85:357, 1978 66. Tolentino FI, Foster CS, Lahav M et al: Toxicity of intravitreous miconazole. Arch Ophthalmol 100:1504, 1982 67. Ketoconazole approved for systemic fungal infections. FDA Drug Bull 11:18, 1981 68. Borgers M, Van den Bossche H, DeBrabander M: The mechanism of action of the new antimycotic ketoconazole. Am J Med 74:2, 1983 69. Utz JP, Drouhet E: Treatment of Candida infections. In Bodey GP, Fainstein V (eds): Candidiasis, p 261. New York: Raven
Press, 1985 70. Jansen PAJ, Symoens JE: Hepatic reactions during ketoconazole treatment. Am J Med 74:80, 1983 71. Lewis JH, Zimmerman HJ, Benson GD, Ishak KG: Hepatic injury associated with ketoconazole therapy: Analysis of 33 cases. Gastroenterology 86:503, 1984 72. Grosso DS, Boyden TW, Pamenter RW et al: Ketoconazole inhibition of testicular secretion of testosterone and displacement
of steroid hormones from serum transport proteins. Antimicrob Agents Chemother 23:207, 1983 73. VanCutsen J: The antifungal activity of ketoconazole. Am J Med 74:9, 1983 74. Drouhet E, Dupont B: Laboratory and clinical assessment of ketoconazole in deep-seated mycoses. Am J Med 74:30, 1983 75. Lechi A, Montesi G, Dean P et al: Ketoconazole: Clinical evaluation in severe fungal infections. Chemioterapia 5:18, 1986 76. Levine HB: Resistance to ketoconazole. Lancet 2:211, 1982 77. Malecaze F, Linas MD, Mathis A et al: Experimental study of intra-ocular penetration of ketoconazole in rabbits. Graefes Arch Clin Exp Ophthalmol 225:163, 1987 78. Savani DV, Perfect JR, Cobo LM, Durack DT: Penetration of new azole compounds into the eye and efficacy in experimental Candida endophthalmitis. Antimicrob Agents Chemother 31:6, 1987 79. Goodman DF, Stern WH: Oral ketoconazole and intraocular amphotericin B for treatment of postoperative Candida parapsilosis endophthalmitis. Arch Ophthalmol 105:172, 1987 80. Yoshizumi MO, Banihashemi AR: Experimental intravitreal ketoconazole in DMSO. Retina 8:210, 1988 81. Investigators' Reference Manual: Fluconazole (UK-49,858) Antifungal, Oral
and Intravenous. Groton, CT: Pfizer Central Research, 1986 82. Humphrey MJ, Jevons S, Tarbit MH: Pharmacokinetic evaluation of UK-49,858, a metabolically stable triazole
antifungal drug in animals and humans. Antimicrob Agents Chemother 28:648, 1985 83. Debryne D, Ryckelynck J: Pharmacokinetics of fluconazole. Clin Pharmacokinet 24:10, 1993 84. O'Day DM, Foulds G, Williams TE et al: Ocular uptake of fluconazole following oral administration. Arch Ophthalmol 108:1006, 1990 85. Mochizuki K, Yamashita Y, Torisaka T et al: Intraocular penetration and effect on the retina of fluconazole. Lens Eye Tox Res 9:537, 1992 86. Foulds G, Brennan DR, Wajszczuk C et al: Fluconazole penetration into cerebrospinal fluid in humans. J Clin Pharmacol 28:363, 1988 87. Boken DJ, Swindells S, Rinaldi MG: Fluconazole-resistant Candida albicans. Clin Infect Dis 17:1018, 1993 88. Wingard JR, Merz WG, Rinaldi MG et al: Increase in Candida krusei infection among patients with bone marrow transplantation and neutropenia
treated prophylactically with fluconazole. N Engl J Med 325:1274, 1991 89. Aust R, Kruse F, Wildfever A et al: Fluconazole level in the aqueous humor after oral drug administration. Ophthalmology 92:829, 1995 90. Filler SG, Crislip MA, Mayer CL, Edwards JE Jr: Comparison of fluconazole and amphotericin B for treatment of disseminated
candidiasis and endophthalmitis in rabbits. Antimicrob Agents Chemother 35:288, 1991 91. Isobe Y, Hatano H: Study of suppressive effect of intravenous fluconazole on endogenous Candida endophthalmitis in rabbits. Jpn J Ophthalmol 36:23, 1992 92. Akler ME, Vellend H, McNeely DM et al: Use of fluconazole in the treatment of candidal endophthalmitis. Clin Infect Dis 20:657, 1995 93. Christmas NJ, Smiddy WE: Vitrectomy and systemic fluconazole for treatment of endogenous fungal
endophthalmitis. Ophthalmic Surg Lasers 27:1012, 1996 94. Laatikainen L, Tuominen M, von Dickhoff K: Treatment of endogenous fungal endophthalmitis with systemic fluconazole
with or without vitrectomy. Am J Ophthalmol 113: 205, 1992 95. Luttrull J, Wan WL, Kubak B et al: Treatment of ocular fungal infections with oral fluconazole. Am J Ophthalmol 119:477, 1995 96. Taniguchi S, Hatano H, Isobe H, Ohno S: Eight cases of endogenous Candida endophthalmitis treated with fluconazole. Curr Aspects Ophthalmol 1254, 1992 97. Urbak SF, Degen T: Fluconazole in the treatment of Candida albicans endophthalmitis. Act Ophthalmol 70:528, 1992 98. Zarbin MA, Becker E, Witcher J et al: Treatment of fungal endophthalmitis with oral fluconazole. Ophthalmic Surg Lasers 27:628, 1996 99. Penk A, Pittrow L: Status of fluconazole in the therapy of Candida endophthalmitis. Mycoses 41(Suppl 2):41, 1998 100. Ohnishi Y, Tawara A, Murata T et al: Postmortem findings 2 weeks after oral treatment for metastatic Candida endophthalmitis with fluconazole. Ophthalmologica 213:341, 1999 101. Nomura J, Ruskin J: Failure of therapy with fluconazole for candidal endophthalmitis. Clin Infect Dis 17:888, 1993 102. Venditti M, Bernardis FD, Micozzi A et al: Fluconazole treatment of catheter-related right-sided endocarditis caused
by Candida albicans and associated with endophthalmitis and folliculitis. Clin Infect Dis 14:422, 1992 103. Schulman JA, Peyman G, Fiscella R et al: Toxicity of intravitreal injection of fluconazole in the rabbit. Can J Ophthalmol 22:304, 1987 104. Su CY, Lin CP, Wang HZ et al: Intraocular use of fluconazole in the management of ocular fungal infection. Kao Hsiung I Hsueh Ko Tsa Chih 15:218, 1999 105. Gakiani JN: Fluconazole, a new antifungal agent. Ann Intern Med 113:177–179, 1990 106. van Wout JW, Novakova I, Verhagen CA et al: The efficacy of itraconazole against fungal infections in neutropenic patients: a
randomized comparative study with amphotericin B. J Infect 22:45, 1991 107. Neppert B, Guthoff R, Heidemann HT: Endogenous Candida endophthalmitis in a drug-dependent patient: Intravenous therapy with
liposome encapsulated amphotericin B. Klin Monatsbl Augenheilkd 201:122, 1992 108. Virata SR, Kylstra JA, Brown JC et al: Worsening of endogenous endophthalmitis during therapy with intravenous
lipid complex amphotericin B. Clin Infect Dis 28:1177, 1999 109. Georgopapadakou NH, Walsh TJ: Antifungal therapy: Chemotherapeutic targets and immunologic strategies. Antimicrob Agents Chemother 40:279, 1996 110. Collignon PJ, Sorrell TC: Disseminated candidiasis: Evidence of a distinctive syndrome in heroin
abusers. Br Med J (Clin Res) 287:861, 1983 111. Hogeweg M, DeJong PTVM: Candida endophthalmitis in heroin addicts. Doc Ophthalmol 55:63, 1983 112. Tarr KH: Candida endophthalmitis and drug abuse. Aust J Ophthalmol 8:303, 1980 113. Elliott JH, O'Day DM, Gutow GS et al: Mycotic endophthalmitis in drug abusers. Am J Ophthalmol 88:66, 1979 114. Aguilar GL, Blumenkranz MS, Egbert PR, McCulley JP: Candida endophthalmitis after intravenous drug abuse. Arch Ophthalmol 97:96, 1979 115. Edwards JE Jr, Foos RY, Malecaze F et al: Candida endophthalmitis after heroin abuse. Mycopathologia 92:73, 1985 116. Gallo J, Playfair J, Gregory-Roberts J et al: Fungal endophthalmitis in narcotic abusers: Medical and surgical therapy
in 10 patients. Med J Aust 142:386, 1985 117. Aabel R Jr, Baster T: Candida albicans endophthalmitis due to catheter tip sepsis. Del Med J 48:121, 1976 118. Rose HD: Venous catheter-associated candidemia. Am J Med Sci 275:265, 1978 119. Graham E, Chignell AH, Eykyn S: Candida endophthalmitis: A complication of prolonged intravenous therapy and antibiotic
treatment. J Infect 13:167, 1986 120. Seelig MS: The role of antibiotics in the pathogenesis of Candida infections. Am J Med 40:887, 1966 121. Kennedy MJ, Volz PA: Effect of various antibiotics on gastrointestinal colonization and dissemination
by Candida albicans. Sabouraudia 23:265, 1985 122. Nahata MC, Davidorf FH, Caldwell JH et al: Candida endophthalmitis associated with total parenteral nutrition. J Parenteral Enteral Nutr 5:150, 1981 123. Dellon AL, Stark WJ, Chretien PB: Spontaneous resolution of endogenous Candida endophthalmitis complicating intravenous hyperalimentation. Am J Ophthal 79:648, 1975 124. Montgomerie JZ, Edwards JB: Association of infection due to Candida albicans with intravenous hyperalimentation. J Infect Dis 137:197, 1978 125. Henderson DK, Edwards JE Jr, Montgomerie JZ: Hematogenous Candida endophthalmitis in patients receiving parenteral hyperalimentation fluids. J Infect Dis 143:655, 1981 126. Schmid S, Marttenet AC, Oelz O: Candida endophthalmitis: Clinical presentation, treatment and outcome in 23 patients. Infection 19:21, 1991 127. Henderson T, Irfan S: Bilateral endogenous Candida endophthalmitis and chorioretinitis following toxic megacolon. Eye 10:755, 1996 128. Airas KA, Nikoskelainen J: Haematogenous Candida endophthalmitis after abdominal surgery. Acta Ophthalmol 65:450, 1987 129. Weickert CH, Richard G: Defekte der Killer-T-Lymphozyten als Ursache einer endogenous Candida albicans-Endophthalmitis. Fortscher Ophthalmol 84:350, 1987 130. Young RC, Bennett JE, Geelhoed GW, Levine AS: Fungemia with compromised host resistance: A study of 70 cases. Am Intern Med 80:605, 1974 131. Wingard JR, Merz WG, Saral R: Candida tropicalis: A major pathogen in immunocompromised patients. Ann Intern Med 91:539, 1979 132. Hawkins C, Armstrong D: Fungal infections in the immunocompromised host. Clin Haematol 13:599, 1984 133. Bodey GP: Infections in cancer patients. Cancer Treat Rev 2:89, 1975 134. Ezdinli EZ, O'Sullivan DD, Wasser LP et al: Oral amphotericin for candidiasis in patients with hematologic neoplasms. JAMA 20:258, 1979 135. Klein JJ, Watanakunakorn C: Hospital-acquired fungemia: Its natural course and clinical significance. Am J Med 67:51, 1979 136. Wade JC: Epidemiology of Candida infections. In Bodey GP (ed): Candidiasis: Pathogenesis, Diagnosis and
Treatment, pp 85–107. New York, Raven Press, 1993 137. Parke DW II, Jones DB, Gentry LO: Endogenous endophthalmitis among patients with candidemia. Ophthalmology 89:789, 1982 138. Brod RD, Flynn HW Jr, Clarkson JG et al: Endogenous Candida endophthalmitis: Management without intravenous amphotericin B. Ophthalmology 96:111, 1989 139. Billson FA, Playfair TJ: The place for vitrectomy in posterior segment infection. Aust J Ophthalmol 9:21, 1981 140. Palmer EA: Endogenous Candida endophthalmitis in infants. Am J Ophthalmol 89:388, 1980 141. Speer ME, Hittner HM, Rudolph AJ: Candida endophthalmitis: A manifestation of candidiasis in the neonate. South Med J 73:1407, 1980 142. Baley JE, Annable WL, Kliegman RM: Candida endophthalmitis in the premature infant. J Pediatr 98:458, 1981 143. Clinch TE, Duker JS, Eagle RC Jr et al: Infantile endogenous Candida endophthalmitis presenting as a cataract. Surv Ophthalmol 34:107, 1989 144. Fleming KO: Candida albicans abscess of retina. Can J Ophthalmol 7:132, 1972 145. Greenwald BD, Tunkel AR, Morgan KM et al: Candidal endophthalmitis after lithotripsy of renal calculi. South Med J 85:773, 1992 146. Chen SJ, Chung YM, Liu JH: Endogenous endophthalmitis after induced abortion. Am J Ophthalmol 125:873, 1998 147. Sixbey JW, Caplan ES: Candida parapsilosis endophthalmitis. Ann Intern Med 89:1010, 1978 148. Guex-Crosier Y, Chave JP, Herbort CP: Postpartum Candida endophthalmitis treated with fluconazole. Ophthalmologica 206:214, 1993 149. Wiesinger EC, Mayerhofer S, Wenisch C et al: Fluconazole in Candida albicans sepsis during pregnancy: Case report and review of the literature. Infection 24:263, 1996 150. Stanbury RM et al: Endogenous Candida endophthalmitis with no apparent predisposing factors. Eye 12:321, 1998 151. Kostick TK, Foster RE, Lowder CY et al: Endogenous endophthalmitis caused by Candida albicans in a healthy women. Am J Ophthalmol 15:593, 1992 152. Flynn HW Jr, Essman TF, Brod RD: Endogenous fungal endophthalmitis. In
Saer J (ed): Proceedings of the 47th Annual Symposium of the New Orleans
Academy of Ophthalmology, pp 297–305. The Hague: Kugler Publications, 1998 153. Elliott AJ: Endophthalmitis in systemic disease. A review of Candida albicans endophthalmitis. Semin Ophthalmol 2:229, 1987 154. He Y et al: An analysis of the cause of misdiagnosis with ocular opportunistic infection. Chung Hua Yen Ko Tsa Chih 33:45, 1997 155. Samiy N et al: Endogenous fungal endophthalmitis. Int Ophthalmol Clin 36:147, 1996 156. Shmuely H, Kremer I, Sagie A, Pitlik S: Candida tropicalis endophthalmitis as the only initial manifestation of pacemaker endophthalmitis. Am J Ophthalmol 123:559, 1997 157. Ellis CA, Spivack ML: The significance of candidemia. Ann Intern Med 67:511, 1967 158. Donahue SP, Greven CM, Zuravleff JJ et al: Intraocular candidiasis in patients with candidemia. Ophthalmology 101:102, 1994 159. Griffin JR, Foos RY, Petit TH: Relationship between Candida endophthalmitis, candidemia, and disseminated candidiasis. In: XXII Concilium
Ophthalmologicum, Paris 1974, vol 2, p 661, 1976 160. McDonnell PJ, McDonnell JM, Brown RH, Green WR: Ocular involvement in patients with fungal infections. Ophthalmology 92:706, 1985 161. Bross J, Talbot GH, Maislon G et al: Risk factors for nosocomial candidemia: A case control study in adults
without leukemia. Am J Med 87:614, 1989 162. Eilard T: Isolation of fungi in blood cultures: A review of fungal infections in
the western part of Sweden 1970-1982. Scand J Infect Dis 19:145, 1987 163. Brooks RG: Prospective study of Candida endophthalmitis in hospitalized patients with candidemia. Arch Intern Med 149:2226, 1989 164. Scherer WJ, Lee K: Implication of early systemic therapy on the incidence of endogenous fungal
endophthalmitis. Ophthalmol 104:1593, 1997 165. Nolla-Salas J, Sitges-Serra A, Leon C et al: Candida endophthalmitis in non-neutropenic patients. Eur J Microbiol Infect Dis 15:503, 1996 166. Enzenauer RW, Calderwood S, Levin AV et al: Screening for fungal endophthalmitis in children at risk. Pediatrics 90:451, 1992 167. Edwards JE Jr, Foos RY, Montgomerie JZ, Guze LB: Ocular manifestation of Review of seventy-six cases of hematogenous Candida endophthalmitis. Review of seventy-six cases of hematogenous Candida endophthalmitis. Candida septicemia. Medicine 53:47, 1974 168. Griffin JR, Pettit TH, Fishman LS, Foos RY: Blood-borne Candida endophthalmitis: A clinical and pathologic study of 21 cases. Arch Ophthalmol 89:450, 1973 169. Jampol LM, Sung J, Walker JD et al: Choroidal neovascularization secondary to Candida albicans chorioretinitis. Am J Ophthalmol 121:643, 1996 170. Shah GK, Fischer D, Fineman MS, Maguire J: Subretinal neovascularization secondary to Candida endophthalmitis: Long-term follow-up after submacular surgery. Retina 19:81, 1999 171. Naoi N et al: Effect of vitrectomy on epiretinal membranes after endogenous fungal endophthalmitis. Jpn J Ophthalmol 119:477, 1996 172. McDonald HR, De Bustros S, Sipperly JO: Vitrectomy for epiretinal membrane with Candida chorioretinitis. Ophthalmology 97:466, 1990 173. Pesin SR, Thomas MA, Smith ME: Combined rhegmatogenous-traction retinal detachment following successful
treatment of Candida chorioretinitis. Arch Ophthalmol 110:1051, 1992 174. Foster RE, Rubsamen PE, Joondeph BC et al: Concurrent endophthalmitis and retinal detachment. Ophthalmology 101:490, 1994 175. Okhravi N, Adamson P, Mant R et al:Polymerase chain reaction and restriction fragment length polymorphism
mediated detection and speciation of Candida sp. causing intraocular infection. Invest Ophthal Vis Sci 39:859, 1998 176. Schulman JA, Peyman GA: Intravitreal corticosteroids as an adjunct in the treatment of bacterial
and fungal endophthalmitis. Retina 12:336, 1992 177. Coats ML et al: Intravitreal corticosteroids in the treatment of exogenous fungal endophthalmitis. Retina 12:46, 1992 178. Young RC, Bennett JE, Vogel CL et al: Aspergillosis: The spectrum of disease in 98 patients. Medicine 49:147, 1970 179. Weishaar PD, Flynn HW Jr, Murray TG et al: Endogenous Aspergillus endophthalmitis: Clinical features and treatment outcomes. Ophthalmology 105:57, 1998 180. Bennett JE: Aspergillus species. In Mandell GL, Bennett JE, Dolin R (eds): Mandell, Douglas, and
Bennett's Principles and Practice of Infectious Diseases, pp 1–12. Vol 2, 4th
ed, chap 238. New York: Churchill Livingstone, 1995 181. Doft BH, Clarkson JG, Rebell G, Forster RK: Endogenous Aspergillus endophthalmitis in drug abusers. Arch Ophthalmol 98:859, 1980 182. Kotwal MR, Rinchhen CZ: Primary aspergillosis with multisystem dissemination. Lancet 1:562, 1981 183. Boldrey EE: Bilateral endogenous Aspergillus endophthalmitis. Retina 1:171, 1981 184. Michelson JB, Freedman SD, Boyden DG: Aspergillus endophthalmitis in a drug abuser. Ann Ophthalmol 14: 1051, 1982 185. Vishniavsky N, Sagar KB, Markowitz SM: Aspergillus fumigatus endocarditis on a normal heart valve. South Med J 76:506, 1983 186. Wilmarth SS, May DR, Roth AM et al: Aspergillus endophthalmitis in an intravenous drug abuser. Ann Ophthalmol 15:470, 1983 187. Roney P, Barr CC, Chun CH, Raff MJ: Endogenous Aspergillus endophthalmitis. Rev Infect Dis 8:955, 1986 188. Bosley TM, Kaufman KJ, Folberg R et al: Disseminated aspergillosis in a patient with ocular reticulum cell sarcoma. Br J Ophthalmol 71:528, 1987 189. Sihota R, Agarwal HC, Grover AK, Sood NN: Aspergillus endophthalmitis. Br J Ophthalmol 71:611, 1987 190. Naylor CD, Shkrum MJ, Edmonds MW, Cholod EJM: Pulmonary aspergillosis and endophthalmitis: Complications of Cushing's
syndrome. Can Med Assoc J 138:719, 1988 191. Lance SE, Fribert TR, Kowalski RP: Aspergillus flavus endophthalmitis and retinitis in an intravenous drug abuser. A therapeutic
success. Ophthalmology 95:947, 1988 192. Weiss JN, Hutchins RK, Balogh K: Simultaneous Aspergillus endophthalmitis and cytomegalovirus retinitis after kidney transplantation. Retina 8:193, 1988 193. Demicco DD, Reichman RC, Violette EJ, Winn WC Jr: Disseminated aspergillosis presenting with endophthalmitis: A case report
and a review of the literature. Cancer 53:1995, 1984 194. Halperin LS, Roseman RL: Successful treatment of a subretinal abscess in an intravenous drug abuser. Arch Ophthalmol 106:1651, 1988 195. Bodoia RD, Kinyoun JL, Qingli L, Bunt-Milam AH: Aspergillus necrotizing retinitis: A clinico-pathologic study and review. Retina 9:226, 1989 196. Naidoff MA, Green WR: Endogenous Aspergillus endophthalmitis occurring after kidney transplant. Am J Ophthamol 79:502, 1975 197. Kammer RB, Utz JP: Aspergillus species endocarditis: The new face of a not-so-rare disease. Am J Med 56:506, 1974 198. Grahm DA, Kinyoun JL, George DP: Endogenous Aspergillus endophthalmitis after lung transplantation. Am J Ophthalmol 119:107, 1995 199. Kalina PH, Campbell RJ: Aspergillus terreus endophthalmitis in a patient with chronic lymphocyctic leukemia. Arch Ophthamol 109:102, 1991 200. Myles WM, Brownstein S, Deschenes J: Clinically unsuspected Aspergillus endophthalmitis. Can J Ophthalmol 32:182, 1997 201. Valluri S, Moorthy RS, Liggett PE, Rao NA: Endogenous Aspergillus endophthalmitis in an immunocompetent individual. Int Ophthalmol 17:131, 1993 202. Matsuo T, Nakagawa H, Matsuo N: Endogenous Aspergillus endophthalmitis associated with periodontitis. Ophthalmologica 209:109, 1995 203. Hunt KE, Glasgow BJ: Aspergillus endophthalmitis: An unrecognized endemic disease in orthotopic liver transplantation. Ophthalmology 103:757, 1996 204. Papanicolaou GA, Meyers BR, Fuchs WS et al: Infectious ocular complications in orthotopic liver transplant patients. Clin Infect Dis 24:1172, 1997 205. Kitahara M, Seth VK, Medoff G, Kobayashi GS: Antimicrobial susceptibility testing of six clinical isolates of Aspergillus. Antimicrob Agents Chemother 9:908, 1976 206. Denning DW, Lee JY, Hostetler JS et al: NIAID mycoses study group multicenter trial of oral itraconazole therapy
for invasive aspergillosis. Am J Med 97:135, 1994 207. Gross JG: Endogenous Aspergillus endophthalmitis-induced endophthalmitis: Successful treatment without
systemic antifungal medication. Retina 12:341, 1992 208. Georgiev VS: Treatment and developmental therapeutics in aspergillosis: I. Amphotericin
B and its derivatives. Respiration 59:291, 1992 209. Rippon JW: Cryptococcosis. In: Medical Mycology. The Pathogenic Fungi and
the Actinomycetes, pp 582–609. 3rd ed. Philadelphia: WB Saunders, 1988 210. Littman ML, Walter JE: Cryptococcosis: Current status. Am J Med 45:922, 1968 211. Chuck SL, Sande MA: Infections with Cryptococcus neoformans in the acquired immunodeficiency syndrome. N Engl J Med 321:794, 1989 212. Henson DJ, Hill AR: Cryptococcal pneumonia: A fulminant presentation. Ann J Med Sci 288:221, 1984 213. Lehmann PF, Morgan RJ, Freimer EH: Infection with Cryptococcus neoformans leading to a pulmonary cryptococcoma and meningitis. J Infect 9:301, 1984 214. Perfect JR, Durack DT, Gallis HA: Cryptococcemia. Medicine 62:98, 1985 215. Okun E, Butler WT: Ophthalmologic complications of cryptococcal meningitis. Arch Ophthalmol 71:52, 1964 216. Custis PH, Haller JA, de Juan E Jr: An unusual case of cryptococcal endophthalmitis. Retina 15:300, 1995 217. Denning DW, Armstrong RW, Fishman M, Stevens DA: Endophthalmitis in a patient with disseminated cryptococcosis and AIDS
who was treated with itraconazole. Rev Infect Dis 13:1126, 1991 218. Ehrhorn J, Grosse G, Staib F, Wollensak J: Intraokulare Cryptococcose. Klin Monatsbl Augenheilkd 168:577, 1976 219. Condon PI, Terry SI, Falconer H: Cryptococcal eye disease. Doc Ophthalmol 44:49, 1977 220. Kumar RK, Lykke AWJ: Disseminated cryptococcosis with ocular involvement. Aust NZ J Med 9:444, 1979 221. Shields JA, Wright DM, Augsburger JJ, Wolkowicz MI: Cryptococcal chorioretinitis. Am J Ophthalmol 89:210, 1980 222. O'Dowd GJ, Frable WJ: Cryptococcal endophthalmitis: Diagnostic vitreous aspiration cytology. Am J Clin Pathol 79:382, 1983 223. Henderly DE, Liggett PE, Rao NA: Cryptococcal chorioretinitis and endophthalmitis. Retina 7:75, 1987 224. Malton ML, Rinkoff JS, Doft BS, Kennerdell JS: Cryptococcal endophthalmitis and meningitis associated with acute psychosis
and exudative retinal detachment. Am J Ophthalmol 104:438, 1987 225. Crump JRC, Elner SG, Elner VM, Kauffman CA: Cryptococcal endophthalmitis: Case report and review. Clin Infect Dis 14:1069, 1992 226. Charle NC, Boxrud CA, Small EA: Cryptococcosis of the anterior segment in acquired immune deficiency syndrome. Ophthalmology 99:813, 1992 227. Kwon-Chung Kj, Bennett JE: Medical Mycology, p 397. Philadelphia: Lea & Febiger, 1992 228. Hiss PW, Shields JA, Augsburger JJ: Solitary retinovitreal abscess as the initial manifestation of cryptococcosis. Ophthalmology 95:162, 1988 229. Sheu SJ, Chen YC, Kuo NW et al: Endogenous cryptococcal endophthalmitis. Ophthalmology 105:377, 1998 230. Spickard A, Butler WT, Anriole V, Utz JP: The improved prognosis of cryptococcal meningitis with amphotericin B therapy. Ann Intern Med 58:66, 1963 231. Dismukes WE: Management of cryptococcosis. Clin Infect Dis 17 (Suppl 2):S507, 1993 232. Bennett JE, Dismukes WE, Duma RJ et al: A comparison of amphotericin B alone and combined with flucytosine in the
treatment of cryptococcal meningitis. N Engl J Med 301:126, 1979 233. Saag MS, Powderly WG, Cloud G et al: Comparison of amphotericin B with fluconazole in the treatment of acute
AIDS-associated cryptococcal meningitis. N Engl J Med 326:83, 1992 234. Bennett JE: The deep mycoses. Cryptococcosis, blastomycosis, histoplasmosis, and
coccidioidomycosis. In Petersdorf RG, Adams RD, Braunwald E
et al (eds): Harrison's Principles of Internal Medicine, pp 1056–1060. 10th
ed. New York: McGraw-Hill, 1983 235. Smith CE: Epidemiology of acute coccidioidomycosis with erythema nodosum (San Juan
or Valley fever). Am J Public Health 30:600, 1940 236. Drutz DJ, Catanzaro A: Coccidioidomycosis. Am Rev Respir Dis 117:559, 1978 237. Stevens DA (ed): Coccidioidomycosis: A Text. New York: Plenum Press, 1980 238. Ampel NM, Wieden MA, Galgiani JN: Coccidioidomycosis: Clinical update. Rev Infect Dis 11:897, 1989 239. Centers for Disease Control. Coccidioidomycosis, United States, 1991-1992. MMWR 42:21, 1993 240. Galgiani JN. Coccidioidomycosis: Changes in clinical expression, serological diagnosis, and
therapeutic options. Clin Infect Dis 14(Suppl 1):S100, 1992 241. Warlick MA, Quan SF, Sobonya RE: Rapid diagnosis of pulmonary coccidioidomycosis. Cytology with potassium
hydroxide preparations.Arch Intern Med 143:723, 1983 242. Kaufman L, Standard P: Improved version of the exoantigen test for identification of Coccidioides immitis and Histoplasma capsulatum cultures. J Clin Microbiol 8:42, 1978 243. Levitt JM: Ocular manifestations of coccidioidomycosis. Am J Ophthalmol 31:1626, 1948 244. Brown WC, Kellenberger RE, Hudson KE: Granulomatous uveitis associated with disseminated coccidioidomycosis. Am J Ophthalmol 45:102, 1958 245. Hagele AJ, Evans DJ, Larwood TR: Primary endophthalmic coccidioidomycosis: Report
of a case of exogenous primary coccidioidomycosis of the eye
diagnosed prior to enucleation. In Aiello L (ed): Coccidioidomycosis, pp 37–39. Tucson: University of Arizona Press, 1967 246. Petit TH, Learn RN, Foos RY: Intraocular coccidioidomycosis. Arch Ophthalmol 77:655, 1967 247. Alexander PB, Coodley EL: Disseminated coccidioidomycosis with intraocular involvement. Am J Ophthalmol 64:283, 1967 248. Green WR, Bennett JE: Coccidioidomycosis: Report of a case with clinical evidence of ocular involvement. Arch Ophthalmol 77:337, 1967 249. Boyden BS, Yee DS: Bilateral coccidioidal choroiditis: A clinicopathologic case report. Trans Am Acad Ophthalmol Otolaryngol 75:1006, 1971 250. Bell R, Font RL: Granulomatous anterior uveitis caused by Coccidioides immitis. Am J Ophthalmol 74:93, 1972 251. Cutler JE, Binder PS, Paul TO, Beamis JF: Metastatic coccidioidal endophthalmitis. Arch Ophthalmol 96:689, 1978 252. Rainin EA, Little HL: Ocular coccidioidomycosis: A clinicopathologic case report. Trans Am Acad Ophthalmol Otolaryngol 76:645, 1972 253. Chandler JW, Kalina RE, Milam DF: Coccidioidal choroiditis following renal transplantation. Am J Ophthalmol 74:1080, 1972 254. Zakka KA, Foos RY, Brown WJ: Intraocular coccidioidomycosis. Surv Ophthalmol 22:313, 1978 255. Blumenkranz MS, Stevens DA: Endogenous coccidioidal endophthalmitis. Ophthalmology 87:974, 1980 256. Glasgow BJ, Brown HH, Foos RY: Miliary retinitis in coccidioidomycosis. Am J Ophthalmol 104:24, 1987 257. Rodenbiker HT, Ganley JP, Galgiani JN, Axline SG: Prevalence of chorioretinal scars associated with coccidioidomycosis. Arch Ophthalmol 99:71, 1981 258. Stone JL, Kalina RE: Ocular coccidioidomycosis. Am J Ophthalmol 116:249, 1993 259. Rodenbiker HT, Ganley JP: Ocular coccidioidomycosis. Surv Ophthalmol 24:263, 1980 260. Moorthy RS, Narsing AR, Sidikaro Y, Foos RY: Coccidioidomycosis iridocyclitis. Ophthalmology 101:1923, 1994 261. Stevens DA, Stiller RL, Williams PL, Sugar AM: Experience with ketoconazole in three major manifestations of progressive
coccidioidomycosis. Am J Med 74:58, 1983 262. Cantanzaro A, Friedman PJ, Schillaci R et al: Treatment of coccidioidomycosis with ketoconazole: An evaluation utilizing
a new scoring system. Am J Med 74:64, 1983 263. Galgiani JN, Catanzaro A, Cloud GA et al: Fluconazole therapy for coccidioidal meningitis: The NIAID Mycoses Study
Group. Ann Intern Med 119:28, 1993 264. Tucker RM, Denning DW, Arathoon EG et al: Itraconazole therapy for nonmeningeal coccidioidomycosis: Clinical and
laboratory observations. J Am Acad Dermatol 23:593, 1990 265. Winn RE: Systemic fungal infections: Diagnosis and treatment. 1. Sporotrichosis. Infect Dis North Am 2:899, 1988 266. Wilson DE, Mann JJ, Bennett JE, Utz JP: Clinical features of extracutaneous sporotrichosis. Medicine 46:265, 1967 267. Lynch PJ. Voorhees JJ, Harrell ER: Systemic sporotrichosis. Ann Intern Med 73:23, 1970 268. Chang AC, Destouet JM, Murphy WA: Musculoskeletal sporotrichosis. Skeletal Radiol 12:23, 1985 269. Satterwhite TK, Kagler WV, Conklin RH et al: Disseminated sporotrichosis. JAMA 240:771, 1978 270. Michelson E: Primary pulmonary sporotrichosis. Ann Thorac Surg 24:83, 1977 271. Matthay RA, Greene WH: Pulmonary infections in the immunocompromised patient. Med Clin North Am 64: 529, 1980 272. Bibler MR, Luber HJ, Glueck HI, Estes SA: Disseminated sporotrichosis in a patient with HIV infection after treatment
for acquired factor VIII inhibitor. JAMA 256:3215, 1986 273. Schenck BR: On refractory subcutaneous abscesses caused by a fungus related to the
sporotricha. Bull Johns Hopkins Hosp 9:286, 1998 274. DeBeurmann CL, Gougerot H: Sporotrichose cachectisante mortelle. Bull Mem Soc Med Hop Paris 26:1046, 1909 275. Francois J. Rysselaere M: Oculomycoses, pp 188–189, 370–380. Springfield, IL: Charles
C Thomas, 1972 276. Levy JH: Intraocular sporotrichosis: Report of a case. Arch Ophthalmol 85:574, 1971 277. Cassady JR, Foerster HC: Sporotrichum schenckii endophthalmitis. Arch Ophthalmol 85:71, 1971 278. Font RL, Jakobiec FA: Granulomatous necrotizing retinochoroiditis caused by Sporotrichum schenckii: Report of a case including immunofluorescence and electron microscopical
studies. Arch Ophthalmol 94:1513, 1976 279. Kurosawa A, Pollack SC, Collins MP et al: Sporothrix schenckii endophthalmitis in a patient with human immunodeficiency virus infection. Arch Ophthalmol 106:376, 1988 280. Agger WA, Caplan RH, Maki DG: Ocular sporotrichosis mimicking mucormycosis in a diabetic. Ann Ophthalmol 10:767, 1978 281. Shelley WB, Sica PA Jr: Disseminated sporotrichosis of skin and bone cured with 5-fluorocytosine: Photosensitivity
as a complication. J Am Dermatol 8:229, 1983 282. Rippon JW: A new ere in antimycotic agents. Arch Dermatol 122:399, 1986 283. Sharkey-Mathis PK, Kauffman CA, Graybill JR et al: Treatment of sporotrichosis with itraconazole: NIAID Mycoses Study Group. Am J Med 95:279, 1993 284. Kauffman CA: Newer developments in therapy for systemic mycoses. Clin Infect Dis 19S:S28, 1994 285. Gilchrist TC, Protozoan dermatitis. J Cutan Dis 12:496, 1894 286. Sarosi GA, Davies SF: Blastomycosis. Am Rev Respir Dis 120:911, 1979 287. Schwarz J, Salfelder K: Blastomycosis: A review of 152 cases. Curr Top Pathol 65:165, 1977 288. Bradsher RW: Blastomycosis. Infect Dis Clin North Am 2:877, 1988 289. Papas PG, Thelkeld MG, Bedsole GD et al: Blastomycosis in immunocompromised patients. Medicine 72:311, 1993 290. Churchill T, Stober AM: A case of systemic blastomycosis. Arch Intern Med 13:568, 1914 291. Schwartz VJ: Intraocular blastomycosis. Arch Ophthalmol 5:581, 1931 292. Casady JV: Uveal blastomycosis. Arch Ophthalmol 35:84, 1946 293. Sinskey RM, Anderson WB: Miliary blastomycosis with metastatic spread to posterior uvea of both
eyes. Arch Ophthalmol 54:602, 1955 294. Font RL, Spaulding AG, Green WR: Endogenous mycotic panophthalmitis caused by Blastomyces dermatitidis: Report of a case and a review of the literature. Arch Ophthalmol 77:217, 1967 295. Bond WI, Sanders CV, Joffe L, Franklin RM: Presumed blastomycosis endophthalmitis. Ann Ophthalmol 14:1183, 1982 296. Lewis H, Aaberg TM, Fary DRB, Stevens TS: Latent disseminated blastomycosis with choroidal involvement. Arch Ophthalmol 106:527, 1988 297. Gottlieb JL, McAllister IL, Guttman FA, Vine AK: Choroidal blastomycosis: A report of 2 cases. Retina 15:248, 1995 298. Li S, Perlman JI, Edward DP, Weiss R: Unilateral Blastomyces dermatitidis endophthalmitis and orbital cellulitis. Ophthalmology 105:1466, 1998 299. Safneck JR, Hogg GA, Napier LB: Endophthalmitis due to Blastomyces dermatitidis: Case report and review of the literature. Ophthalmology 97:212, 1990 300. Vida L, Moel SA: North American blastomycosis with orbital involvement. Am J Ophthalmol 77:240, 1974 301. McManus EJ, Jones JM: The use of ketoconazole in the treatment of blastomycosis. Am Rev Respir Dis 133:141, 1986 302. Dismukes WE, Bradsher RW, Cloud GA et al: Itraconazole therapy for blastomycosis and histoplasmosis. Am J Med 93:489, 1992 303. Rippon JW: Medical mycology: The pathogenic fungi and the pathogenic actinomycetes. In
Freeman BA (ed): Burrow's Textbook of Microbiology, pp 760–774. 21st
ed. Philadelphia: WB Saunders, 1979 304. Goodwin RA Jr, Desperez RM: Histoplasmosis: State of the art. Am Rev Respir Dis 117:929, 1978 305. Kauffman CA, Isreal AS et al: Histoplasmosis in immunosuppressed patients. Am J Med 64:923, 1978 306. Specht CS, Mitchell KT, Baum AE, Gupta M: Ocular histoplasmosis with retinitis in a patient with the acquired immune
deficiency syndrome. Ophthalmology 98:1356, 1991 307. Macher A, Rodrigues MM, Kaplan W et al: Disseminated bilateral chorioretinitis due to Histoplasma capsulatum in a patient with the acquired immunodeficiency syndrome. Ophthalmology 92:1159, 1985 308. Goldstein BG, Buettner H: Histoplasmic endophthalmitis: A clinicopathologic correlation. Arch Ophthalmol 101: 774, 1983 309. Klintworth GK, Hollingsworth AS, Lusman PA, Bradford WD: Granulomatous choroiditis in a case of disseminated histoplasmosis. Histopathologic
demonstration of Histoplasma capsulatum in choroidal lesions. Arch Ophthalmol 90:45, 1973 310. Scholz R, Green WR, Kutys R et al: Histoplasma capsulatum in the eye. Ophthalmology 91:1100, 1984 311. Schwartz J, Salfelder K, Viloria JE: Histoplasma capsulatum in vessels of the choroid. Ann Ophthalmol 9:633, 1977 312. Schwartz J: Granulomatous histoplasmosis of the eye: A rare disease. Int Ophthalmol Clin 15:65, 1975 313. Weingeist TA, Watzke RC: Ocular involvement by Histoplasma capsulatum. Int Ophthalmol Clin 23:33, 1982 314. Ganley JP: Epidemiologic characteristics of presumed ocular histoplasmosis. Acta Ophthalmol Scand Suppl 119:1, 1973 315. Katz BJ, Scott WE, Folk JC: Acute histoplasmosis choroiditis in 2 immunocompetent brothers. Arch Ophthalmol 115:1470, 1997 316. Davies SF: Serodiagnosis of histoplasmosis. Semin Respir Infect 1:9, 1986 317. Slama TG: Treatment of disseminated and progressive cavitary histoplasmosis
with ketoconazole. Am J Med 70, 1983 318. Sarosi GA Davies SF: Therapy for fungal infections. Mayo Clin Proc 69:1111, 1994 319. Goodwin RA Jr, Shapiro JL, Thurman GH et al: Disseminated histoplasmosis: Clinical and pathologic correlations. Medicine 59:1, 1980 320. Pfeifer JD, Grande MG, Thomas MA et al: Endogenous Pseudallescheria boydii endophthalmitis: Clinicopathologic findings in two cases. Arch Ophthalmol 109:1714, 1991 321. Taravella MJ, Johnson DW, Petty JG et al: Infectious posterior scleritis caused by Pseudallescheria boydii. Clinicopathologic findings. Ophthalmology 104:1312, 1997 322. McGuire TW, Bullock JD, Bullock JD Jr et al: Fungal endophthalmitis: An experimental study with review of 17 human ocular
cases. Arch Ophthalmol 109:1289, 1991 323. Lieberman TW, Ferry AP, Bottone EJ: Fusarium solani endophthalmitis without primary corneal involvement. Am J Ophthalmol 88:764, 1979 324. Cho CT, Vats TS, Lowman JT et al: Fusarium solani infection during treatment for acute leukemia. J Pediatr 83: 1028, 1973 325. Mayayo E, Guarro J, Pujol I: Endogenous endophthalmitis by Fusarium solani: An animal experimental model. Med Mycol 36:249, 1998 326. Glasgow BJ, Engstrom RE Jr, Holland GN et al: Bilateral endogenous Fusarium endophthalmitis associated with acquired immunodeficiency syndrome. Arch Ophthalmol 114:873, 1996 327. Gabriele P, Hutchins RK: Fusarium endophthalmitis in an intravenous drug abuser. Am J Ophthalmol 122:119, 1996 328. Louie T, Baba F, Shulman M, Jimenez-Lucho V: Endogenous endophthalmitis due to Fusarium: Case report and review. Clin Infect Dis 18:585, 1994 329. Pittke EC, Hertenstein B, Bachor R: Orbitale und okulare Mucormykose. Klin Monatsbl Augenheilkd 1900:530, 1987 330. Minogue MJ et al: Cure of Paecilomyces endophthalmitis with multiple intravitreal injections of amphotericin
B. Arch Ophthalmol 107:1281, 1989 331. Lam DS et al: Endogenous fungal endophthalmitis caused by Paecilomyces variotii. Eye 13:113, 1999 332. Okhravi N et al: Paecilomyces lilacinus endophthalmitis with secondary keratitis: A case report and literature
review. Arch Ophthalmol 115:1320, 1997 333. Swan SK, Wagner RA, Myers JP, Cinelli AB: Mycotic endophthalmitis caused by Pencillium sp after parenteral drug abuse. AM J Ophthalmol 100:408, 1985 334. Pavan PR et al: Endogenous endophthalmitis due to Bipolaris hawaiiensis in a patient with acquired immunodeficiency syndrome. Am J Ophthalmol 116:644, 1993 335. Walsh TJ, Orth DH, Shapiro CM et al: Metastatic fungal chorioretinitis developing during Trichosporon sepsis. Ophthalmology 89:152, 1982 336. Gregor RJ, Chong CA, Augsburger JJ et al: Endogenous Nocardia asteroides subretinal abscess diagnosed by transvitreal fine-needle aspiration biopsy. Retina 9:118, 1989 337. Ferry AP, Font RL, Weiberg RS et al: Nocardial endophthalmitis: Report of two cases studied histopathologically. Br J Ophthalmol 72:55, 1988 338. Mamalis N, Daily MJ, Ros D: Presumed intraocular nocardiosis in a cardiac-transplant patient. Ann Ophthalmol 20:271, 1988 339. Bullock JD: Endogenous ocular nocardiosis: A clinical and experimental study. Trans Am Ophthalmol Soc 81:451, 1983 340. Ishibashi Y, Watanabe R, Hommura S et al: Endogenous Nocardia asteroides endophthalmitis in a patient with systemic lupus erythematosus. Br J Ophthalmol 74:433, 1990 341. Wallace RJ JR, Steele LC, Sunter G, Smith JM: Antimicrobial susceptibility patterns of Nocardia asteroides. Antimicrob Agents Chemother 32:1776, 1988 |